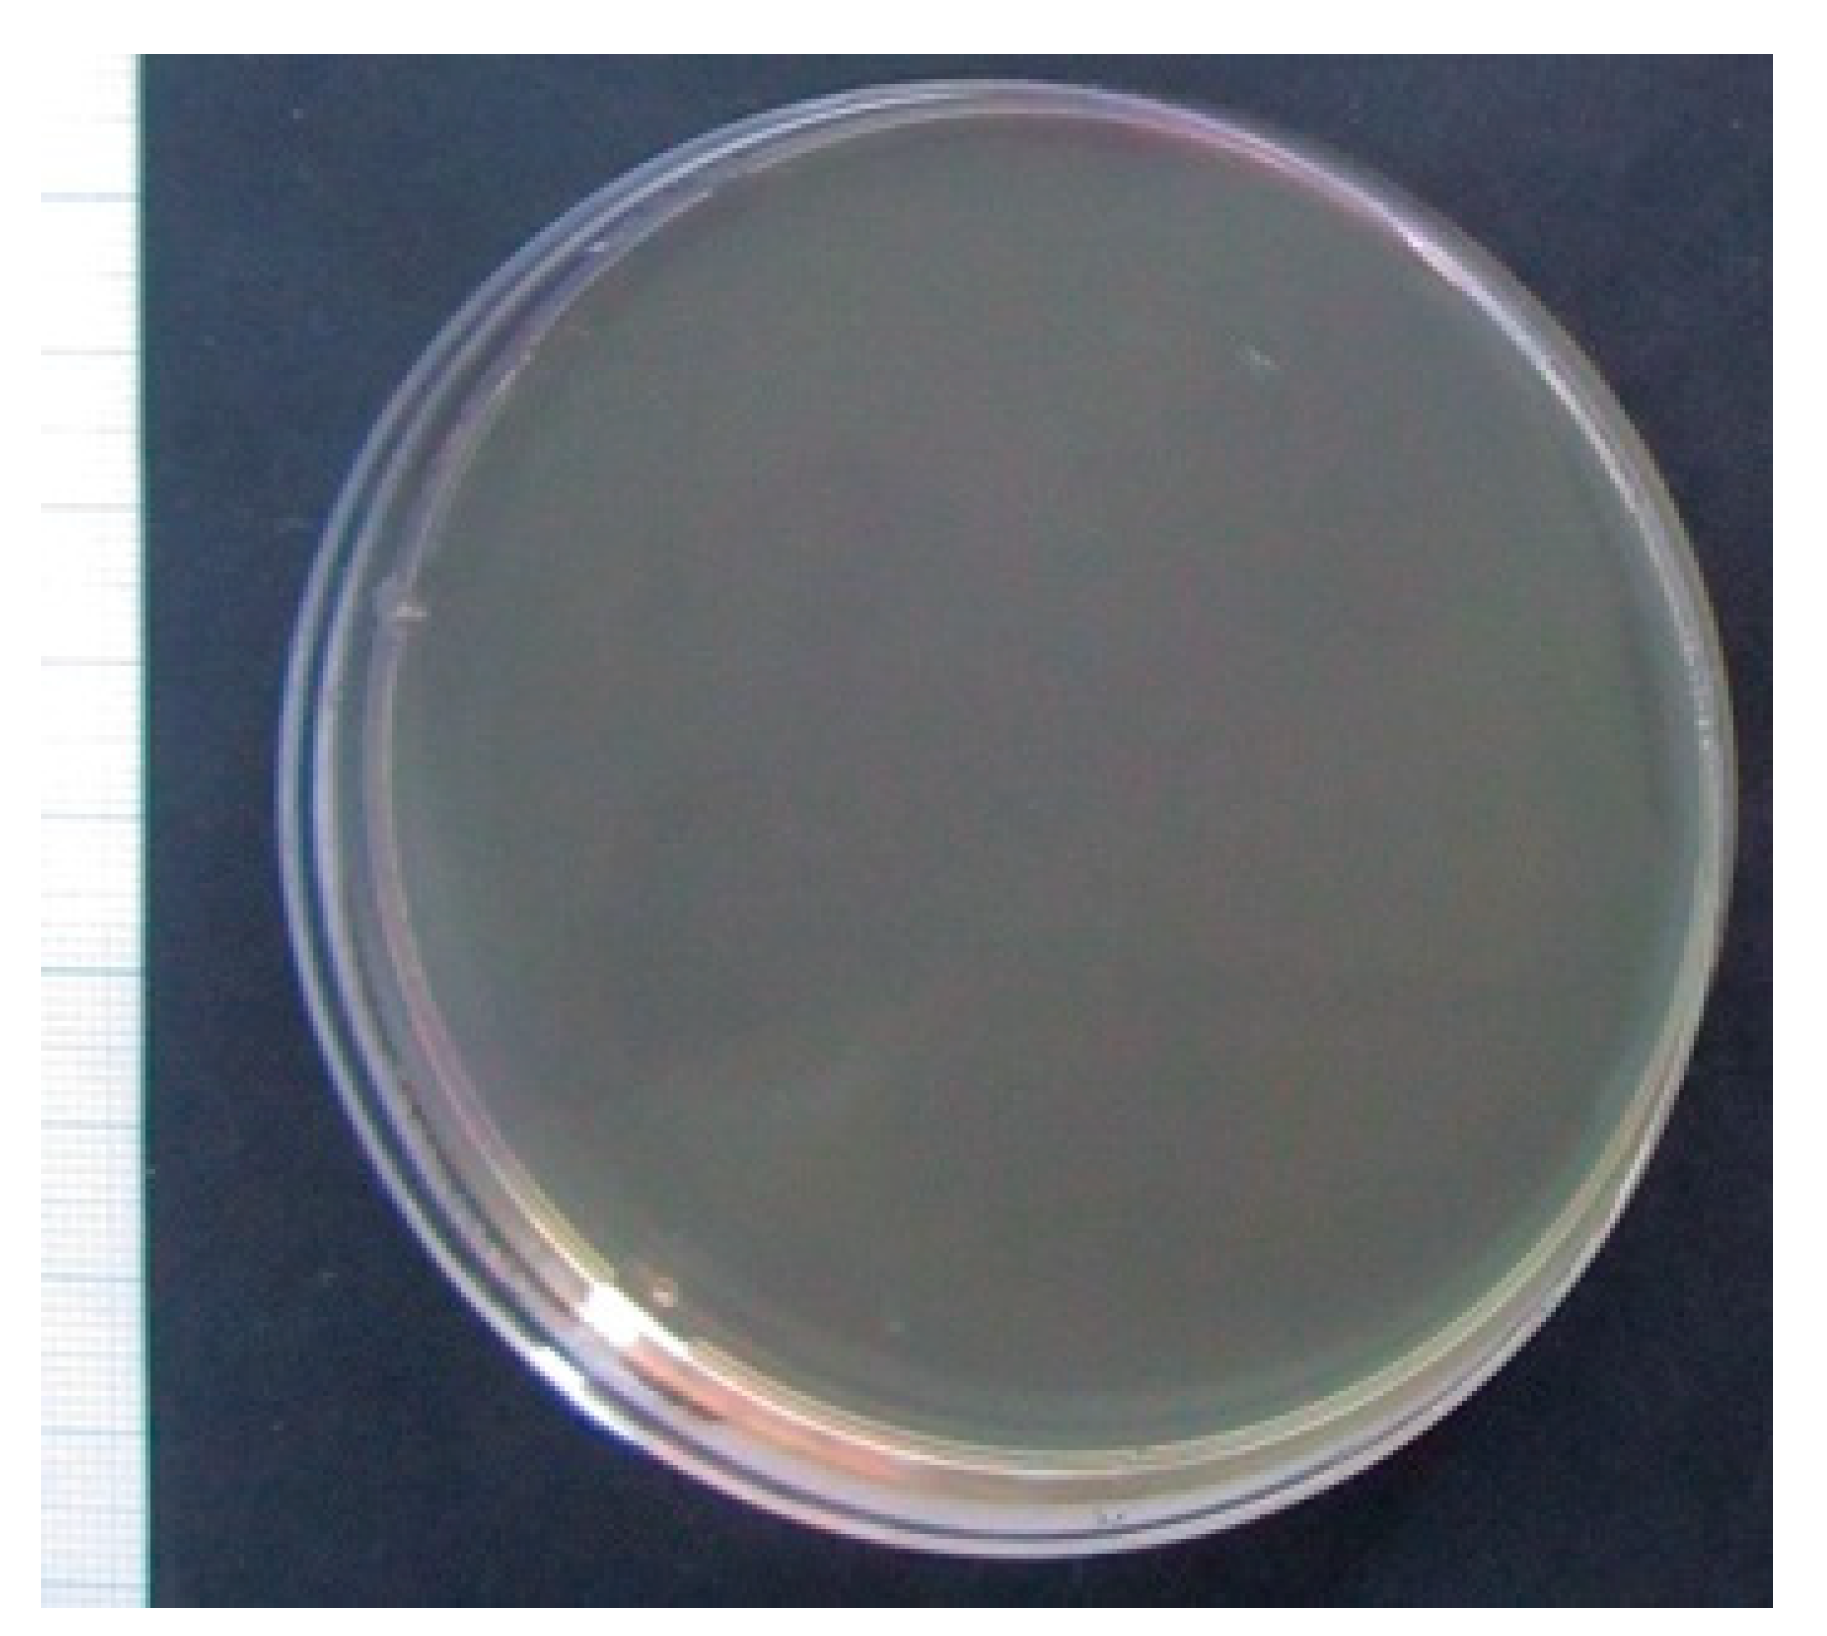
Molecules 24 03680 g002 Molecules 24 03680 g002
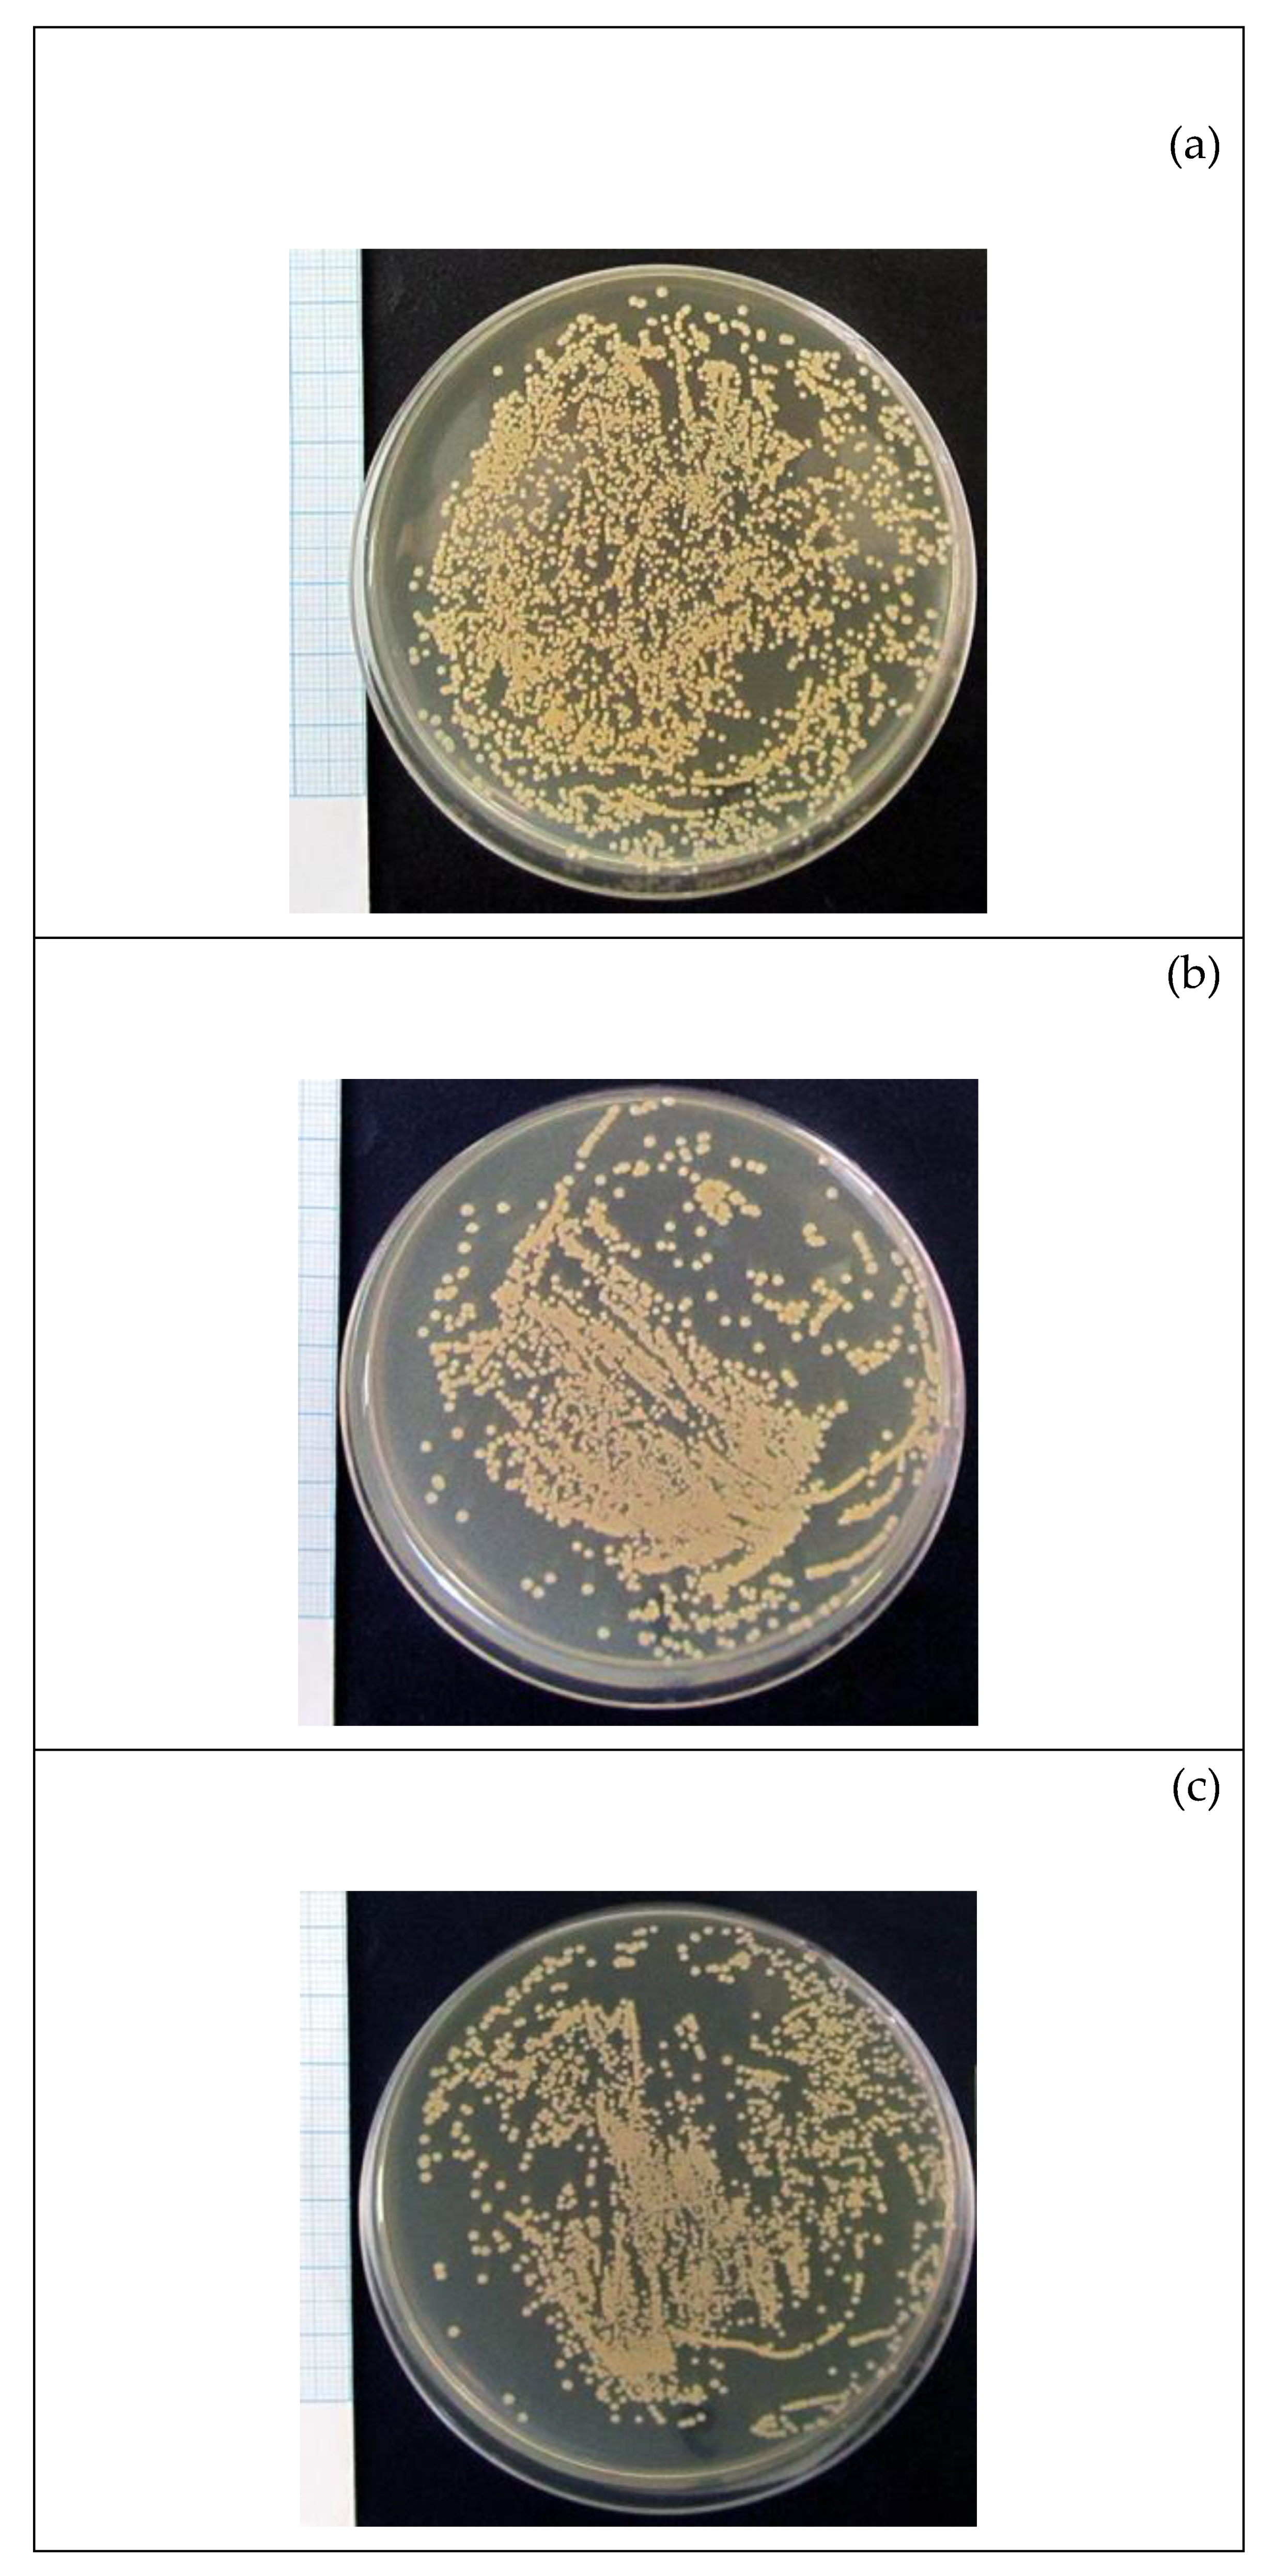
Molecules 24 03680 g003 Molecules 24 03680 g003

Comparative In Vitro Evaluation of Antibacterial and Osteogenic Activity of Polysaccharide and Flavonoid Fractions Isolated from the leaves of Saussurea controversa
Abstract
1. Introduction
2. Results
2.1. The Structure of Components
2.2. Study of Cytotoxicity and Osteogenic Differentiation of hAMMSCs In Vitro
2.3. Study of Bacterial Cell Growth In Vitro
3. Discussion
4. Materials and Methods
4.1. Plant Material
4.2. Extraction and Isolation
4.3. Polysaccharides Study
4.4. Human Cell Culturing and In Vitro Staining
4.5. Bacterial Cell Growth In Vitro
4.6. Statistical Analysis
5. Conclusions
Author Contributions
Funding
Acknowledgments
Conflicts of Interest
References
- Parvizi, J.; Gehrke, T.; Chen, A.F. Proceedings of the international consensus on periprosthetic joint infection. Bone Joint J. 2013, 95-B, 1450–1452. [Google Scholar] [CrossRef]
- Cushnie, T.P.T.; Lamb, A.J. Antimicrobial activity of flavonoids. Int. J. Antimicrob. Agents 2005, 26, 343–356. [Google Scholar] [CrossRef]
- Rigano, D.; Formisano, C.; Basile, A.; Lavitola, A.; Senatore, F.; Rosselli, S.; Bruno, M. Antibacterial activity of flavonoids and phenylpropanoids from marrubium globosum ssp. libanoticum. Phytother. Res. 2007, 21, 395–397. [Google Scholar] [CrossRef]
- Xie, Y.; Yang, W.; Tang, F.; Chen, X.; Ren, L. Antibacterial activities of flavonoids: Structure-activity relationship and mechanism. Curr. Med. Chem. 2015, 22, 132–149. [Google Scholar] [CrossRef] [PubMed]
- Farhadi, F.; Khameneh, B.; Iranshahi, M.; Iranshahy, M. Antibacterial activity of flavonoids and their structure–activity relationship: An update review. Phytother. Res. 2019, 33, 13–40. [Google Scholar] [CrossRef] [PubMed]
- Wang, H.B. Cellulase-assisted extraction and antibacterial activity of polysaccharides from the dandelion Taraxacum officinale. Carbohydr. Polym. 2014, 103, 140–142. [Google Scholar] [CrossRef] [PubMed]
- Yu, W.; Chen, H.; Xiang, Z.; He, N. Preparation of polysaccharides from ramulus mori, and their antioxidant, anti-Inflammatory and antibacterial activities. Molecules 2019, 24, 856. [Google Scholar] [CrossRef] [PubMed]
- Zhao, J.-L.; Zhang, M.; Zhou, H.-L. Microwave-assisted extraction, purification, partial characterization, and bioactivity of polysaccharides from Panax ginseng. Molecules 2019, 24, 1605. [Google Scholar] [CrossRef]
- Xie, F.; Wu, C.-F.; Lai, W.-P.; Yang, X.-J.; Cheung, P.-Y.; Yao, X.-S.; Leung, P.-C.; Wong, M.-S. The osteoprotective effect of Herba epimedii (HEP) extract in vivo and in vitro. Evid. Based Complement. Alternat. Med. 2005, 2, 353–361. [Google Scholar]
- Shou, D.; Zhang, Y.; Shen, L.; Zheng, R.; Huang, X.; Mao, Z.; Yu, Z.; Wang, N.; Zhu, Y. Flavonoids of herba epimedii enhances bone repair in a rabbit model of chronic osteomyelitis during post-infection treatment and stimulates osteoblast proliferation in vitro. Phytother. Res. 2017, 31, 330–339. [Google Scholar] [CrossRef]
- Kim, C.S.; Ha, H.K.; Song, K.Y. Therapeutic Agent or Osteoporosis Comprising an Active Ingredient of Quercetin Derivatives. US Patent 0162247, 19 August 2004. [Google Scholar]
- Adluri, R.S.; Zhan, L.; Bagchi, M.; Maulik, N.; Maulik, G. Comparative effects of a novel plant-based calcium supplement with two common calcium salts on proliferation and mineralization in human osteoblast cells. Mol. Cell. Biochem. 2010, 340, 73–80. [Google Scholar] [CrossRef] [PubMed]
- Yamamoto, N.; Tokuda, H.; Kuroyanagi, G.; Kainuma, S.; Ohguchi, R.; Fujita, K.; Matsushima-Nishiwaki, R.; Kozawa, O.; Otsuka, T. Amplification by (-)-epigallocatechingallate and chlorogenic acid of TNF-α-stimulated interleukin-6 synthesis in osteoblasts. Int. J. Mol. Med. 2015, 36, 1707–1712. [Google Scholar] [CrossRef] [PubMed]
- Aoshima, Y.; Hasegawa, Y.; Hasegawa, S.; Nagasaka, A.; Kimura, T.; Hashimoto, S.; Torii, Y.; Tsukagoshi, N. Isolation of GnafC, a polysaccharide constituent of Gnaphalium affine, and synergistic effects of GnafC and ascorbate on the phenotypic expression of osteoblastic MC3T3-E1 cells. Biosci. Biotechnol. Biochem. 2003, 67, 2068–2074. [Google Scholar] [CrossRef] [PubMed]
- Du, L.; Nong, N.; Zhao, J.; Peng, X.; He, J.; Wu, Y.; Shi, X.; Zong, S.; Zeng, G.F. Polygonatum sibiricum polysaccharide inhibits osteoporosis by promoting osteoblast formation and blocking osteoclastogenesis through Wnt/β-catenin signalling pathway. Sci. Rep. 2016, 6, 1–12. [Google Scholar] [CrossRef] [PubMed]
- Avdeeva, E.; Shults, E.; Rybalova, T.; Reshetov, Y.; Porokhova, E.; Sukhodolo, I.; Litvinova, L.; Shupletsova, V.; Khaziakhmatova, O.; Khlusov, I.; et al. Chelidonic acid and its derivatives from Saussurea Controversa: Isolation, structural elucidation and influence on the osteogenic differentiation of multipotent mesenchymal stromal cells in vitro. Biomolecules 2019, 9, 189. [Google Scholar] [CrossRef] [PubMed]
- Avdeeva, Y.Y.; Zorkaltsev, M.A.; Zavadovskaya, V.D.; Slizovsky, G.V.; Krasnov, E.A.; Pekhenko, V.G.; Stepanov, M.Y. Study of the activity extracts from Saussurea controversa and Filipendula ulmaria in experimental osteomyelitis with three-phase scintigraphy. Bull. Sib. Med. 2015, 14, 5–9. [Google Scholar]
- Avdeeva, E.; Shults, E.; Skorokhodova, M.; Reshetov, Y.; Porokhova, E.; Sukhodolo, I.; Krasnov, E.; Belousov, M. Flavonol glycosides from Saussurea controversa and their efficiency in experimental osteomyelitis. Planta Med. Int. Open 2018, 5, e24–e29. [Google Scholar] [CrossRef][Green Version]
- Liu, J.; Willför, S.; Xu, C. A review of bioactive plant polysaccharides: Biological activities, functionalization, and biomedical applications. Bioact. Carbohydr. Diet. Fibre 2015, 5, 31–61. [Google Scholar] [CrossRef]
- Hwang, Y.-H.; Ha, H.; Kim, R.; Cho, C.-W.; Song, Y.-R.; Hong, H.-D.; Kim, T. Anti-osteoporotic effects of polysaccharides isolated from persimmon leaves via osteoclastogenesis inhibition. Nutrients 2018, 10, 901. [Google Scholar] [CrossRef]
- Tite, T.; Popa, A.C.; Balescu, L.M.; Bogdan, I.M.; Pasuk, I.; Ferreira, J.M.F.; Stan, G.E. Cationic substitutions in hydroxyapatite: Current status of the derived biofunctional effects and their in vitro interrogation methods. Materials 2018, 11, 2081. [Google Scholar] [CrossRef]
- Rodríguez, J.P.; Ríos, S.; González, M. Modulation of the proliferation and differentiation of human mesenchymal stem cells by copper. J. Cell. Biochem. 2002, 85, 92–100. [Google Scholar] [CrossRef] [PubMed]
- Ratner, B.D.; Hoffman, A.S.; Schoen, F.J.; Lemons, J.E. Biomaterials Science: An Introduction to Materials in Medicine, 3rd ed.; Elsevier Science Publishing Co., Inc.: San Diego, CA, USA, 2012. [Google Scholar]
- Mohan, S.K.; Veeraraghavan, V.P.; Jainu, M. Effect of pioglitazone, quercetin and hydroxy citric acid on extracellular matrix components in experimentally induced non-alcoholic steatohepatitis. Iran. J. Basic Med. Sci. 2015, 18, 832–836. [Google Scholar] [PubMed]
- Lin, Y.C.; Tsai, P.H.; Lin, C.Y.; Cheng, C.H.; Lin, T.H.; Lee, K.P.; Huang, K.Y.; Chen, S.H.; Hwang, J.J.; Kandaswami, C.C.; et al. Impact of flavonoids on matrix metalloproteinase secretion and invadopodia formation in highly invasive A431-III cancer cells. PLoS ONE 2013, 8, e71903. [Google Scholar] [CrossRef] [PubMed]
- Fabre, G.; Bayach, I.; Berka, K.; Paloncýová, M.; Starok, M.; Rossi, C.; Duroux, J.L.; Otyepka, M.; Trouillas, P. Synergism of antioxidant action of vitamins E, C and quercetin is related to formation of molecular associations in biomembranes. Chem. Commun. (Camb.) 2015, 51, 7713–7716. [Google Scholar] [CrossRef]
- Aerts, F.; Wagemaker, G. Mesenchymal Stem Cell Engineering and Transplantation. In Genetic Engineering of Mesenchymal Stem Cells; Nolta, J.A., Ed.; Springer: Dordrecht, The Netherlands, 2006; pp. 1–44. [Google Scholar]
- Middleton, E.; Kandaswami, C.; Theoharides, T.C. The effects of plant flavonoids on mammalian cells: Implications for inflammation, heart disease, and cancer. Pharm. Rev. 2000, 52, 673–751. [Google Scholar]
- Ohashi, K.; Fujiwara, S.; Mizuno, K. Roles of the cytoskeleton, cell adhesion and rho signalling in mechanosensing and mechanotransduction. J. Biochem. 2017, 161, 245–254. [Google Scholar] [CrossRef]
- Khalfallah, A.; Berrehal, D.; Bensouici, C.; Kabouche, A.; Semra, Z.; Voutquenne-Nazabadioko, L.; Magid, A.A.; Kabouche, Z. Flavonoids, cytotoxic, antioxidant and antibacterial activities of Evaxpygmaea. Pharm. Biol. 2017, 55, 2292–2296. [Google Scholar] [CrossRef]
- Kaneko, T.; Baba, N. Protective effect of flavonoids on endothelial cells against linoleic acid hydroperoxide-induced cytotoxicity. Biosci. Biotechnol. Biochem. 1999, 63, 323–328. [Google Scholar] [CrossRef]
- Zhang, W.; Wang, J.; Chen, Y.; Zheng, H.; Xie, B.; Sun, Z. Flavonoid compounds and antibacterial mechanisms of different parts of white guava (Psidium guajava L. cv. Pearl). Nat. Prod. Res. 2018, 1–5. [Google Scholar] [CrossRef]
- Ahmed, H.; Moawad, A.; Owis, A.; AbouZid, S.; Ahmed, O.M. Flavonoids of Calligonum polygonoids and their cytotoxicity. Pharm. Biol. 2016, 54, 1–8. [Google Scholar] [CrossRef]
- Beltagy, A.M. Microwave-assisted extraction of flavonoids and profiling flavonoid cytotoxicity against Hep-G2 human cancer cell line. Int. J. Pharm. Sci. Res. 2017, 8, 4573–4581. [Google Scholar]
- Dzoyem, J.P.; Tchamgoue, J.; Tchouankeu, J.C.; Kouam, S.F.; Choudhary, M.I.; Bakowsky, U. Antibacterial activity and cytotoxicity of flavonoids compounds isolated from Pseudarthria hookeri Wight&Arn. (Fabaceae). S. Afr. J. Bot. 2018, 114, 100–103. [Google Scholar]
- Thilakarathna, S.H.; Rupasinghe, V.H.P. Flavonoid bioavailability and attempts for bioavailability enhancement. Nutrients 2013, 5, 3367–3387. [Google Scholar] [CrossRef] [PubMed]
- Wang, Z.-M.; Li, L.; Guo, S.; Cai, M.-Y. Review on structure-activity relationship of active polysaccharides. Xiandai Huagong Mod. Chem. Ind. 2002, 22, 18–21. [Google Scholar]
- Lowry, O.H.; Rosbrough, N.J.; Farr, A.L.; Randall, R.J. Protein measurement with the Folin phenol reagent. J. Biol. Chem. 1951, 193, 265–270. [Google Scholar]
- Dubois, M.; Gilles, K.A.; Hamilton, J.K. Colorimetric method for determination of sugars and related substances. Analyt. Chem. 1956, 28, 350–356. [Google Scholar] [CrossRef]
- Rovkina, K.I.; Krivoshchekov, S.V.; Guryev, A.M.; Yusubov, M.S.; Belousov, M.V. Water-soluble polysaccharides of alfalfa (Medicago sativa (Fabaceae)) of Flora of krasnoyarsk krai. Russ. J. Bioorg. Chem. 2018, 44, 854–859. [Google Scholar] [CrossRef]
- Zuk, P.A.; Zhu, M.; Mizuno, H.; Huang, J.; Futrell, J.W.; Katz, A.J.; Benhaim, P.; Lorenz, H.P.; Hedrick, M.H. Multilineage cells from human adipose tissue: Implications for cell-based therapies. Tissue Eng. 2001, 7, 211–228. [Google Scholar] [CrossRef]
- Dominici, M.; Le Blanc, K.; Mueller, I.; Slaper-Cortenbach, I.; Marini, F.C.; Krause, D.S.; Deans, R.J.; Keating, A.; Prockop, D.J.; Horwitz, E.M. Minimal criteria for defining multipotent mesenchymal stromal cells. The international society for cellular therapy position statement. Cytotherapy 2006, 8, 315–317. [Google Scholar] [CrossRef]
- Bourin, P.; Bunnell, B.A.; Casteilla, L.; Dominici, M.; Katz, A.J.; March, K.L.; Redl, H.; Rubin, J.P.; Yoshimura, K.; Gimble, J.M. Stromal cells from the adipose tissue-derived stromal vascular fraction and culture expanded adipose tissue-derived stromal/stem cells: A joint statement of the International Federation for Adipose Therapeutics and Science (IFATS) and the International Society for Cellular Therapy (ISCT). Cytotherapy 2013, 15, 641–648. [Google Scholar]
- Karlov, A.V.; Usikov, V.D.; Khlusov, I.A.; Khohlov, A.V. Dynamometrische einschatzung der fixations festigkeit von bioimplantaten in kaninchen wirbeln. Biomed. Tech. 2000, 45, 125–126. [Google Scholar] [CrossRef]
- Kim, I.S.; Song, Y.M.; Cho, T.H.; Park, Y.D.; Lee, K.B.; Noh, I.; Weber, F.; Hwang, S.J. In vitro response of primary human bone marrow stromal cells to recombinant human bone morphogenic protein-2 in the early and late stages of osteoblast differentiation. Dev. Growth Differ. 2008, 50, 553–564. [Google Scholar] [PubMed]
Sample Availability: Samples of the polysaccharides and flavonoids are available from the authors. |

| Group, n = 3 | Dose, mg/L | Number of Viable Cells, ×103 cells/mL | Number of Apoptotic Cells, ×103 cells/mL | Number of Necrotic Cells, ×103 cells/mL | |
|---|---|---|---|---|---|
| 1 | Stem cells cultured on plastic surface without compounds (control) | 0 | 83 (48–91) | 2.4 (0.4–3.0) | 9.5 (2–14) |
| 2 | Cells + F–SC | 10 | 88 (62–93) | 6.7 (2.9–6.8) | 26 (13–27) |
| 30 | 83 (67–89) | 3.2 (2.1–3.5) | 19.5 (11–25) | ||
| 50 | 70 (59–82) | 2.6 (1.9–3.3) | 12 (8–17) | ||
| 3 | Cells + PS–SC | 10 | 15 (11–30) U1 < 0.05 U3 < 0.05 | 0.8 (0.3–1.6) U3 < 0.05 | 1.6 (1.5–5.2) U3 < 0.05 |
| 30 | 21 (18–42) U1 < 0.05 U3 < 0.05 | 3 (2.1–3.8) U2 < 0.05 | 9 (6.3–13.7) U2 < 0.05 | ||
| 50 | 11 (9–23) U1 < 0.05 U3 < 0.05 | 0.7 (0.2–1.8) U2 < 0.05 U3 < 0.05 | 1.5 (1.3–4.8) U2 < 0.05 U3 < 0.05 | ||
| Group, n = 3 | Dose, mg/L | The Number of Sites of Cell Culture Mineralization | U Criterion, Statistical Significance | Average Area of the Mineralization Sites, mm2 | U Criterion, Statistical Significance | Optical Density (OD) of the Mineralization Sites, c.u. | U Criterion, Statistical Significance | |
|---|---|---|---|---|---|---|---|---|
| 1 | Stem cells cultured on plastic surface without compound (control) | 0 | 14 ± 2 | - | 0.027 (0.013–0.095) | - | 8.10 (5.29–11.37) | - |
| 2 | Cells + F-SC | 10 | 54 ± 5 | U1 < 0.05 | 0.039 (0.019–0.093) | - | 28.26 (23.73–36.05) | U1 < 0.05 |
| 30 | 21 ± 4 | U1 < 0.05 U2 < 0.05 | 0.029 (0.007–0.051) | - | 32.87 (30.24–38.14) | U1 < 0.05 | ||
| 50 | 53 ± 3 | U1 < 0.05 U2 < 0.05 | 0.048 (0.020-0.083) | U2 < 0.05 | 41.81 (35.61–51.83) | U1 < 0.05 | ||
| 3 | Cells + PS-SC | 10 | 47 ± 3 | U1 < 0.05 | 0.037 (0.011–0.179) | - | 45.91 (35.47–55.51) | U1 < 0.05 U3 < 0.05 |
| 30 | 118 ± 5 | U1 < 0.05 U2 < 0.05 U3 < 0.05 | 0.025 (0.009–0.090) | - | 48.72 (41.93–60.07) | U1 < 0.05 U3 < 0.05 | ||
| 50 | 128 ± 13 | U1 < 0.05 U2 < 0.05 U3 < 0.05 | 0.018 (0.009–0.064) | U2 < 0.05 U3 < 0.05 | 55.93 (44.10–67.33) | U1 < 0.05 U3 < 0.05 | ||
| Group, n = 3 | Dose, g/L | Area of the Bacterial Colonies, % | U Criterion, Statistical Significance | |
|---|---|---|---|---|
| 1 | Control bacterial culture without compounds | 0 | 45.2 (42.8–46.4) | - |
| 2 | S. aureus + F-SC | 6.25 | 36.1 (35.4–36.7) | U1 < 0.05 |
| 3 | S. aureus + PS-SC | 25 | 34.2 (33.6–35.4) | U1 < 0.05 |
© 2019 by the authors. Licensee MDPI, Basel, Switzerland. This article is an open access article distributed under the terms and conditions of the Creative Commons Attribution (CC BY) license (http://creativecommons.org/licenses/by/4.0/).
Share and Cite
Khlusov, I.; Avdeeva, E.; Shupletsova, V.; Khaziakhmatova, O.; Litvinova, L.; Porokhova, E.; Reshetov, Y.; Zvereva, I.; Mushtovatova, L.; Karpova, M.; et al. Comparative In Vitro Evaluation of Antibacterial and Osteogenic Activity of Polysaccharide and Flavonoid Fractions Isolated from the leaves of Saussurea controversa. Molecules 2019, 24, 3680. https://doi.org/10.3390/molecules24203680
Khlusov I, Avdeeva E, Shupletsova V, Khaziakhmatova O, Litvinova L, Porokhova E, Reshetov Y, Zvereva I, Mushtovatova L, Karpova M, et al. Comparative In Vitro Evaluation of Antibacterial and Osteogenic Activity of Polysaccharide and Flavonoid Fractions Isolated from the leaves of Saussurea controversa. Molecules. 2019; 24(20):3680. https://doi.org/10.3390/molecules24203680
Chicago/Turabian StyleKhlusov, Igor, Elena Avdeeva, Valeria Shupletsova, Olga Khaziakhmatova, Larisa Litvinova, Ekaterina Porokhova, Yaroslav Reshetov, Irina Zvereva, Lyudmila Mushtovatova, Mariia Karpova, and et al. 2019. "Comparative In Vitro Evaluation of Antibacterial and Osteogenic Activity of Polysaccharide and Flavonoid Fractions Isolated from the leaves of Saussurea controversa" Molecules 24, no. 20: 3680. https://doi.org/10.3390/molecules24203680
APA StyleKhlusov, I., Avdeeva, E., Shupletsova, V., Khaziakhmatova, O., Litvinova, L., Porokhova, E., Reshetov, Y., Zvereva, I., Mushtovatova, L., Karpova, M., Guryev, A., Sukhodolo, I., & Belousov, M. (2019). Comparative In Vitro Evaluation of Antibacterial and Osteogenic Activity of Polysaccharide and Flavonoid Fractions Isolated from the leaves of Saussurea controversa. Molecules, 24(20), 3680. https://doi.org/10.3390/molecules24203680

